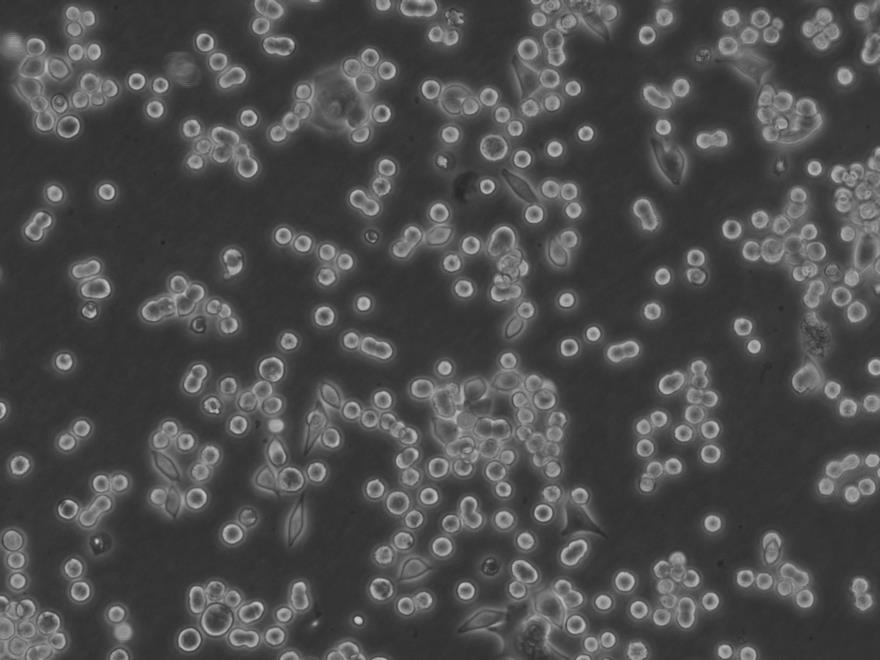
IPEC-J2 Cells猪小肠上皮细胞批次新|送STR图谱

"IPEC-J2 Cells猪小肠上皮细胞批次新|送STR图谱
细胞别名:IPECJ2; Intestinal Porcine Epithelial Cell line-J2
传代比例:1:2-1:4(首次传代建议1:2)
生长特性:贴壁生长
换液周期:每周2-3次
RN Cells;背景说明:详见相关文献介绍;传代方法:1:2-1:3传代;每周换液2-3次。;生长特性:贴壁或悬浮,详见产品说明书部分;形态特性:详见产品说明书;相关产品有:SCC-4细胞、4T1细胞、NCI-H1963细胞
ROS-17/2.8 Cells;背景说明:骨肉瘤;ACI 9935;传代方法:1:2-1:3传代;每周换液2-3次。;生长特性:贴壁;形态特性:详见产品说明书;相关产品有:MDA2B细胞、COLO 824细胞、GM03570E细胞
SW 900 Cells;背景说明:详见相关文献介绍;传代方法:1:2-1:3传代;每周换液2-3次。;生长特性:贴壁或悬浮,详见产品说明书部分;形态特性:详见产品说明书;相关产品有:H295R-S1细胞、H1563细胞、Tb1.Lu细胞
在细胞培养操作中,每一个步骤都可能影响细胞系的命运。有时,细胞换液后突然死亡,这让科研人员困惑不已。那么,究竟是什么原因导致了这种情况呢?首先,换液操作过程中的不当处理是一个常见因素。例如,使用的移液器如果没有校准准确,吸取或添加培养液的量过多或过少,都可能使细胞所处的环境渗透压发生变化。细胞在渗透压失衡的环境中,水分子会快速进出细胞,导致细胞肿胀或皱缩,最终死亡。此外,如果在吸取旧培养液时过于靠近细胞层,容易造成细胞的机械性损伤,破坏细胞的完整性,使其无法维持正常的生理功能。其次,培养液的成分和质量也至关重要。新配制的培养液若在成分比例上出现偏差,如某些营养物质浓度过高或过低,可能无法满足细胞的生长需求,导致细胞因营养缺乏或中毒而死亡。而且,培养液若在储存或处理过程中受到污染,从而迅速致使细胞死亡。再者,培养环境的变化不容忽视。换液时,比如,温度过高会使细胞内蛋白质变性,温度过低则会降低细胞的活性和代谢速率;二氧化碳浓度的改变会影响培养液的酸碱度,进而干扰细胞的正常生理活动。所以细胞换液后死亡是多种因素综合作用的结果。
IPEC-J2 Cells猪小肠上皮细胞批次新|送STR图谱
┈订┈购(技术服务)┈热┈线:1┈3┈6┈4┈1┈9┈3┈0┈7┈9┈1【微信同号】┈Q┈Q:3┈1┈8┈0┈8┈0┈7┈3┈2┈4;
背景信息:详见相关文献介绍
产品包装:复苏发货:T25培养瓶(一瓶)或冻存发货:1ml冻存管(两支)
公司细胞系主要引进ATCC、DSMZ、JCRB、KCLB、RIKEN、ECACC等细胞库,细胞系体外培养,它们会成长为单层细胞,附着或紧贴在培养瓶上,或悬浮在体外的溶液中,细胞系复苏周期短,公司细胞系状态良好,饱满,有光泽等优点。EDTA的作用:许多人不用胰酶,只用EDTA,或者用胰酶/EDTA联合作用。这里要明白,胰酶切割细胞外基质的一些负责粘连和附着的蛋白,而EDTA通过螯合Ca离子,作用于整联蛋白的活性,所以EDTA的作用更加温和。有的人在胰酶里添加一些EDTA,或者对付特别难消化的细胞,添加多一些EDTA,就是这个道理。一般不要试图延长消化时间(如果10min还消化不下来的话),而应该想其它办法。
来源说明:细胞主要来源ATCC、ECACC、DSMZ、RIKEN等细胞库
物种来源:人源、鼠源等其它物种来源
IPEC-J2 Cells猪小肠上皮细胞批次新|送STR图谱
┈订┈购(技术服务)┈热┈线:1┈3┈6┈4┈1┈9┈3┈0┈7┈9┈1【微信同号】┈Q┈Q:3┈1┈8┈0┈8┈0┈7┈3┈2┈4;
DI TNC-1 Cells;背景说明:详见相关文献介绍;传代方法:1:2传代;生长特性:贴壁生长;形态特性:成纤维母细胞样;相关产品有:MXI细胞、KP-4细胞、SW948细胞
NCI-SNU-C2A Cells;背景说明:详见相关文献介绍;传代方法:每周两次换液;生长特性:松散附着、多单元的聚合;形态特性:上皮细胞样;相关产品有:SU 86.86细胞、TE4细胞、TE4细胞
SNU-719 Cells;背景说明:胃癌;男性;传代方法:1:2-1:3传代;每周换液2-3次。;生长特性:贴壁;形态特性:详见产品说明书;相关产品有:HcerEpic细胞、P36细胞、Sp2/0-Ag14细胞
BNL.1ME A.7R.1 Cells;背景说明:肝;上皮细胞;BALB/c;传代方法:1:2-1:3传代;每周换液2-3次。;生长特性:贴壁;形态特性:详见产品说明书;相关产品有:NCI-H740细胞、NCI-SNU-C1细胞、3T3-Swiss albino细胞
形态特性:上皮细胞样
为什么培养的细胞要及时传代?体外培养的细胞大多具有生长接触抑制的性,也就是说当一个细胞被其他细胞包围的时候,它就会停止生长,及时传代后,细胞的生长得以继续。培养细胞生长减慢的原因在哪些?其解决办法有哪些?可能的原因有:更换了不同的培养或血清;培养中一些细胞生长必需成分如谷眈肢或生长因子等耗尽或缺乏或己被破坏;培养物中有少量细菌或真菌污染;试剂保存不当;比较新培养与原培养成分,比较新血清与旧血清等,找出其它可能的原因。解决办法:增加起始培养细胞浓度;让细胞逐渐适应新培养;换入新鲜配制培养;补加谷酷肢或生长因子等;用无抗生素培养培养,如发现污染,去弃培养物,或用抗生素除菌;血清需保存在5℃到20℃; 培养需在2-8℃避光保存;含血清完全培养在2-8℃保存,并在2周内用完;分离培养物,检测支原体。冷冻管应如何解冻?取出冷冻管后,须立即放入37℃水槽中快速解冻,轻摇冷冻管使其在1-2分钟内大部分融化,别注意,需残留一小块冰块,就可拿到超净工作台操作细胞,用75%酒精消毒冻存管,用新鲜培养基将细胞转移至培养瓶。另外冷冻管由桶中取出解冻时,必须注意安全,预防冷冻管爆裂。
2PK-3 Cells;背景说明:详见相关文献介绍;传代方法:1:2-1:3传代;每周换液2-3次。;生长特性:贴壁或悬浮,详见产品说明书部分;形态特性:详见产品说明书;相关产品有:OC-3-VGH细胞、MLA 144细胞、A 2780 CP细胞
MN60 Cells;背景说明:B细胞白血病;男性;传代方法:1:2-1:3传代;每周换液2-3次。;生长特性:悬浮;形态特性:详见产品说明书;相关产品有:COLO-679细胞、VMRCRCZ细胞、WISH细胞
MARC 145 Cells;背景说明:胚肾;自发永生;传代方法:1:2-1:3传代;每周换液2-3次。;生长特性:贴壁;形态特性:详见产品说明书;相关产品有:CoCL2细胞、CP70细胞、T-T细胞
H-2347 Cells;背景说明:详见相关文献介绍;传代方法:1:2-1:6传代,每周2-3次。;生长特性:贴壁生长;形态特性:上皮样;相关产品有:Anglne细胞、WM-239细胞、TCC Sup细胞
NCI-H2198 Cells;背景说明:详见相关文献介绍;传代方法:1:2-1:3传代;每周换液2-3次。;生长特性:贴壁或悬浮,详见产品说明书部分;形态特性:详见产品说明书;相关产品有:Ca761细胞、OVCAR5细胞、DSL6A/C1细胞
CCK-81 Cells;背景说明:详见相关文献介绍;传代方法:1:2-1:3传代;每周换液2-3次。;生长特性:贴壁或悬浮,详见产品说明书部分;形态特性:详见产品说明书;相关产品有:H6c7细胞、MA-c细胞、Mouse Colon 38细胞
MCFs Cells;背景说明:心肌;成纤维 Cells;传代方法:1:2-1:3传代;每周换液2-3次。;生长特性:贴壁;形态特性:详见产品说明书;相关产品有:HEK (AD293)细胞、PG-4 S+L-细胞、Ramos.G6.C10细胞
GP-293 Cells;背景说明:详见相关文献介绍;传代方法:1:2-1:3传代;每周换液2-3次。;生长特性:贴壁或悬浮,详见产品说明书部分;形态特性:详见产品说明书;相关产品有:Mo7e细胞、NCI-522细胞、LCMS细胞
SK-LU-1 Cells;背景说明:该细胞系源于一位60岁的白人女性患者的肺腺癌组织。;传代方法:1:2传代;每周换液2次。;生长特性:贴壁生长;形态特性:上皮细胞样;相关产品有:OCI-Ly 3细胞、LN 382细胞、211H细胞
TGW Cells;背景说明:详见相关文献介绍;传代方法:1:2传代;生长特性:贴壁生长;形态特性:神经元细胞;相关产品有:Clone Y-1细胞、ARO细胞、RCC-JF细胞
M-07e Cells;背景说明:详见相关文献介绍;传代方法:1:2-1:3传代;每周换液2-3次。;生长特性:贴壁或悬浮,详见产品说明书部分;形态特性:详见产品说明书;相关产品有:KP-2细胞、TGW-nu-1细胞、NCI-H2108细胞
MOLT.4 Cells;背景说明:MOLT-4与MOLT-3来源于一名19岁的男性急性淋巴细胞性白血病的复发患者,该患者前期接受过多种药物联合化疗。MOLT-4细胞系为T淋巴细胞起源,p53基因的第248位密码子有一个G→A突变,不表达p53,不表达免疫球蛋白或EB病毒;可产生高水平的末端脱氧核糖转移酶;表达CD1(49%),CD2(35%),CD3A(26%)B(33%)C(34%),CD4(55%),CD5(72%),CD6(22%),CD7(77%)。;传代方法:1:2传代;生长特性:悬浮生长;形态特性:淋巴母细胞样;圆形;相关产品有:H295细胞、A2780S细胞、DCS细胞
COLO206 Cells;背景说明:详见相关文献介绍;传代方法:1:2-1:3传代;每周换液2-3次。;生长特性:贴壁或悬浮,详见产品说明书部分;形态特性:详见产品说明书;相关产品有:NALM-6-M1细胞、H-II-E-C3细胞、SU-DHL-16细胞
AK Cells;背景说明:详见相关文献介绍;传代方法:1:2传代;生长特性:贴壁生长;形态特性:成纤维细胞;相关产品有:Virginia Mason Research Center-Renal Cancer Z细胞、HGMC细胞、TE-13细胞
NCIH358 Cells;背景说明:1981年从一位开始化疗之前的患者的肿瘤组织中分离建株。超微结构研究表明细胞质中有Clara细胞的特征结构细胞表达主要的肺表面结合蛋白SP-A的蛋白和RNA。不表达SP-B和SP-C。他们在软琼脂中的克隆形成效率为0.83%。;传代方法:消化3-5分钟。1:2。3天内可长满。;生长特性:贴壁生长;形态特性:上皮样;相关产品有:NOMO-1细胞、Giant Cell Tumor细胞、COS-1细胞
HUSMC Cells;背景说明:子宫;平滑肌细胞;女性;传代方法:1:2-1:3传代;每周换液2-3次。;生长特性:贴壁;形态特性:详见产品说明书;相关产品有:H-847细胞、Hep G2细胞、COLO 320F细胞
SF-539 BT Cells;背景说明:胶质瘤;女性;传代方法:1:2-1:3传代;每周换液2-3次。;生长特性:贴壁;形态特性:详见产品说明书;相关产品有:SCL1细胞、Liver-02细胞、RMC细胞
43L Cells(提供STR鉴定图谱)
Abcam Jurkat PIM2 KO Cells(提供STR鉴定图谱)
ALZ.41 Cells(提供STR鉴定图谱)
BayGenomics ES cell line RRK106 Cells(提供STR鉴定图谱)
BayGenomics ES cell line XL074 Cells(提供STR鉴定图谱)
CAF-Clan I Cells(提供STR鉴定图谱)
┈订┈购(技术服务)┈热┈线:1┈3┈6┈4┈1┈9┈3┈0┈7┈9┈1【微信同号】┈Q┈Q:3┈1┈8┈0┈8┈0┈7┈3┈2┈4;
DA00504 Cells(提供STR鉴定图谱)
DM14 [Human OCSCC] Cells(提供STR鉴定图谱)
GM03133 Cells(提供STR鉴定图谱)
NCI-H711 Cells;背景说明:详见相关文献介绍;传代方法:1:2-1:3传代;每周换液2-3次。;生长特性:贴壁或悬浮,详见产品说明书部分;形态特性:详见产品说明书;相关产品有:P3/X63/Ag8细胞、BEL-7405细胞、EoL-1-cell细胞
PECAPJ34 Cells;背景说明:详见相关文献介绍;传代方法:1:2传代;生长特性:贴壁生长;形态特性:上皮样;相关产品有:BT细胞、C518细胞、Hs611T细胞
SK-OV-433 Cells;背景说明:卵巢癌;女性;传代方法:1:2-1:3传代;每周换液2-3次。;生长特性:贴壁;形态特性:详见产品说明书;相关产品有:KYSE-450细胞、WIL2S细胞、DMS 273细胞
D-341 Med Cells;背景说明:详见相关文献介绍;传代方法:每周换液2-3次。;生长特性:悬浮生长;形态特性:髓母细胞样;相关产品有:OVCAR8/ADR细胞、EOC-20细胞、HuCC-T1细胞
IPEC-J2 Cells猪小肠上皮细胞批次新|送STR图谱
LAD2 Cells;背景说明:肥大 Cells;传代方法:1:2-1:3传代;每周换液2-3次。;生长特性:悬浮;形态特性:详见产品说明书;相关产品有:IPEC-1细胞、RGB细胞、WERIRb1细胞
H-526 Cells;背景说明:详见相关文献介绍;传代方法:每周换液2-3次。;生长特性:悬浮生长 ;形态特性:上皮细胞;相关产品有:HMEC-1细胞、GM05384细胞、Mono-Mac-1细胞
NCI-H1781 Cells;背景说明:详见相关文献介绍;传代方法:1:2-1:3传代;每周换液2-3次。;生长特性:贴壁或悬浮,详见产品说明书部分;形态特性:详见产品说明书;相关产品有:253JBV细胞、NHEK细胞、ESC-410细胞
IOSE 80 Cells;背景说明:卵巢;上皮细胞;SV40转化;女性;传代方法:1:2-1:3传代;每周换液2-3次。;生长特性:贴壁;形态特性:详见产品说明书;相关产品有:H2330细胞、NALM-6细胞、FHC细胞
M-O7e Cells;背景说明:详见相关文献介绍;传代方法:1:2-1:3传代;每周换液2-3次。;生长特性:贴壁或悬浮,详见产品说明书部分;形态特性:详见产品说明书;相关产品有:HCE-T细胞、EFO27细胞、NCIH548细胞
CAL 78 Cells;背景说明:软骨肉瘤;男性;传代方法:1:2-1:3传代;每周换液2-3次。;生长特性:贴壁;形态特性:详见产品说明书;相关产品有:SNU-387细胞、U138-MG细胞、MB49细胞
H-748 Cells;背景说明:详见相关文献介绍;传代方法:3-4天换液1次。;生长特性:悬浮生长 ;形态特性:详见产品说明书;相关产品有:Mel624细胞、MARC 145细胞、SK-RC 39细胞
CCD18Co Cells;背景说明:结肠;成纤维细胞;女性;传代方法:1:2-1:3传代;每周换液2-3次。;生长特性:贴壁;形态特性:详见产品说明书;相关产品有:HLE B-3细胞、NCI-H1385细胞、HBL 100细胞
HDQ-P1 Cells;背景说明:详见相关文献介绍;传代方法:1:2-1:3传代;每周换液2-3次。;生长特性:贴壁或悬浮,详见产品说明书部分;形态特性:详见产品说明书;相关产品有:HCT.116细胞、A-673细胞、HIEC细胞
5C12 [Mouse hybridoma against human HMGB1] Cells(提供STR鉴定图谱)
SK.OV.3 Cells;背景说明:SK-OV-3由G.Trempe和L.J.Old在1973年从卵巢肿瘤病人的腹水分离得到。 此细胞对肿瘤坏死因子和几种细胞毒性药物包括白喉毒素、顺铂和阿霉素均耐受。 在裸鼠中致瘤,且形成与卵巢原位癌一致的中度分化的腺癌。;传代方法:1:2-1:3传代;每周换液2-3次。;生长特性:贴壁;形态特性:上皮细胞样;相关产品有:HME1细胞、NUGC2细胞、Emory University-2细胞
GM10624 Cells(提供STR鉴定图谱)
HAP1 CD47 (-) 1 Cells(提供STR鉴定图谱)
HCET Cells;背景说明:角膜上皮细胞;Ad-SV40转化;女性;传代方法:1:2-1:3传代;每周换液2-3次。;生长特性:贴壁;形态特性:详见产品说明书;相关产品有:NCI H295R细胞、FM88细胞、EA.hy 926细胞
T2 (174 x CEM.T2) Cells;背景说明:详见相关文献介绍;传代方法:1:3—1:6传代,每周换液2—3次;生长特性:悬浮生长;形态特性:淋巴母细胞样;相关产品有:Bowes melanoma cells细胞、NCIH2347细胞、GP2d细胞
BC-3-H-I Cells;背景说明:详见相关文献介绍;传代方法:1:2-1:3传代;每周换液2-3次。;生长特性:贴壁或悬浮,详见产品说明书部分;形态特性:详见产品说明书;相关产品有:CHP126细胞、Lewis Lung细胞、NBL-3细胞
TGBC-11-TKB Cells;背景说明:详见相关文献介绍;传代方法:1:2传代;生长特性:贴壁生长;形态特性:上皮细胞;相关产品有:RPMI7951细胞、J82 COT细胞、LC-1 sq细胞
TW01 Cells;背景说明:鼻咽癌;传代方法:1:2-1:3传代;每周换液2-3次。;生长特性:贴壁;形态特性:详见产品说明书;相关产品有:WEHI3B细胞、CCD966SK细胞、SKRC-39细胞
293 H Cells;背景说明:详见相关文献介绍;传代方法:1:2-1:3传代;每周换液2-3次。;生长特性:贴壁或悬浮,详见产品说明书部分;形态特性:详见产品说明书;相关产品有:RGC5细胞、NCI-H2291细胞、H-125细胞
OS-RC-2 Cells;背景说明:来源于日本人的肾脏肿瘤细胞。 可以移植到裸鼠。;传代方法:1:2传代;生长特性:贴壁生长;形态特性:上皮细胞样;相关产品有:NUGC2细胞、SF-767细胞、3T6细胞
M-1 myeloid leukemia Cells;背景说明:髓系白血病;SL;传代方法:1:2-1:3传代;每周换液2-3次。;生长特性:悬浮;形态特性:详见产品说明书;相关产品有:NCI H69细胞、H69/P细胞、RAT2细胞
HG03879 Cells(提供STR鉴定图谱)
ILKM2 Lyn Cells(提供STR鉴定图谱)
LTAg2B subclone cl.2C Cells(提供STR鉴定图谱)
ND01284 Cells(提供STR鉴定图谱)
PC9-OR1 Cells(提供STR鉴定图谱)
Ubigene HCT 116 NTSR1 KO Cells(提供STR鉴定图谱)
WAe001-A-5 Cells(提供STR鉴定图谱)
HG02943 Cells(提供STR鉴定图谱)
TM3 Cells;背景说明:TM3细胞在LH作用下cAMP产量升高,但对促卵泡激素没有响应。对LH的响应持续时间与血清批次有关。在LH存在下,细胞可以代谢胆固醇。检测发现鼠痘病毒阴性。;传代方法:1:2传代;生长特性:贴壁生长;形态特性:上皮样;相关产品有:HRCEC细胞、NS653细胞、HSC-1细胞
SKOV-3 Cells;背景说明:SK-OV-3由G.Trempe和L.J.Old在1973年从卵巢肿瘤病人的腹水分离得到。 此细胞对肿瘤坏死因子和几种细胞毒性药物包括白喉毒素、顺铂和阿霉素均耐受。 在裸鼠中致瘤,且形成与卵巢原位癌一致的中度分化的腺癌。;传代方法:1:2-1:3传代;每周换液2-3次。;生长特性:贴壁;形态特性:上皮细胞样;相关产品有:MOLT 3细胞、MADB-106细胞、G-292细胞
hTERT-HME-1 Cells;背景说明:详见相关文献介绍;传代方法:1:2-1:3传代;每周换液2-3次。;生长特性:贴壁或悬浮,详见产品说明书部分;形态特性:详见产品说明书;相关产品有:293-EBNA细胞、HGF-1细胞、KOPN-8细胞
Mahlavu Cells;背景说明:肝癌;女性;传代方法:1:2-1:3传代;每周换液2-3次。;生长特性:贴壁;形态特性:详见产品说明书;相关产品有:Sp2/0-Ag14细胞、MB468细胞、HO-1-N-1细胞
H3255 Cells;背景说明:详见相关文献介绍;传代方法:1:2传代;生长特性:贴壁生长 ;形态特性:详见产品说明书;相关产品有:RCC-4细胞、KP4细胞、KU-812F细胞
H3255 Cells;背景说明:详见相关文献介绍;传代方法:1:2传代;生长特性:贴壁生长 ;形态特性:详见产品说明书;相关产品有:RCC-4细胞、KP4细胞、KU-812F细胞
HMEC Cells;背景说明:乳腺;上皮 Cells;传代方法:1:2-1:3传代;每周换液2-3次。;生长特性:贴壁;形态特性:详见产品说明书;相关产品有:BE(2)-M17细胞、SKGT4细胞、QGP 1细胞
LS-411N Cells;背景说明:详见相关文献介绍;传代方法:1:2传代;每周2次;生长特性:贴壁生长;形态特性:上皮样;相关产品有:N-87细胞、H1648细胞、MESSA细胞
H358 Cells;背景说明:1981年从一位开始化疗之前的患者的肿瘤组织中分离建株。超微结构研究表明细胞质中有Clara细胞的特征结构细胞表达主要的肺表面结合蛋白SP-A的蛋白和RNA。不表达SP-B和SP-C。他们在软琼脂中的克隆形成效率为0.83%。;传代方法:消化3-5分钟。1:2。3天内可长满。;生长特性:贴壁生长;形态特性:上皮样;相关产品有:P3/NS1/1-Ag4.1细胞、NK-92 transfected with MFG-hIL2细胞、ACC-2细胞
A2780 CP70 Cells;背景说明:卵巢癌;女性;传代方法:1:2-1:3传代;每周换液2-3次。;生长特性:贴壁;形态特性:详见产品说明书;相关产品有:Cor L88细胞、B958细胞、HELA-GFP细胞
H2591 Cells;背景说明:上皮样间皮瘤;男性;传代方法:1:2-1:3传代;每周换液2-3次。;生长特性:贴壁;形态特性:详见产品说明书;相关产品有:Hep G2-Luc细胞、SKOV-3细胞、CEMC7细胞
H341 Cells;背景说明:详见相关文献介绍;传代方法:每周换液2-3次。;生长特性:悬浮生长;形态特性:髓母细胞样;相关产品有:MTEC1细胞、Radiation Effects Research Foundation-Lung Cancer-MS细胞、MDAMB435细胞
HEK-293-F Cells;背景说明:详见相关文献介绍;传代方法:1:2传代;生长特性:贴壁生长;悬浮生长;形态特性:上皮细胞样;相关产品有:201T细胞、NCI-H1048细胞、STO细胞
Co 205 Cells;背景说明:该细胞系是1957年由T.U.Sample等从患有结肠癌的70岁男性白人的腹水中分离的。该病人在取腹水样品前已用5-尿嘧啶治疗4~6周。角蛋白免疫过氧化物酶染色阳性;产生CEA、IL10。;传代方法:1:2传代;生长特性:贴壁生长;形态特性:上皮样;相关产品有:Hs1.Tes细胞、KNS81细胞、KYSE 270细胞
H1694 Cells;背景说明:详见相关文献介绍;传代方法:3-4天换液1次。;生长特性:悬浮生长;形态特性:聚团悬浮;相关产品有:beta TC6细胞、TE671细胞、CCRF/CEM/0细胞
SCRP1702i Cells(提供STR鉴定图谱)
MH7A Cells;背景说明:关节;成纤维细胞;SV40转化;女性;传代方法:1:2-1:3传代;每周换液2-3次。;生长特性:贴壁;形态特性:详见产品说明书;相关产品有:HOK细胞、BHP-10细胞、H1793细胞
MDBK (NBL-1) Cells;背景说明:详见相关文献介绍;传代方法:1:2传代;生长特性:贴壁生长 ;形态特性:详见产品说明书;相关产品有:H378细胞、RIN-m细胞、COR-L23/P细胞
751-NA Cells;背景说明:详见相关文献介绍;传代方法:1:2-1:3传代;每周换液2-3次。;生长特性:贴壁或悬浮,详见产品说明书部分;形态特性:详见产品说明书;相关产品有:EFO27细胞、HeLa.S3细胞、138MG细胞
TE1 Cells;背景说明:详见相关文献介绍;传代方法:消化3-5分钟。1:2。3天内可长满。;生长特性:贴壁生长;形态特性:上皮样;相关产品有:H-2228细胞、COLO-320HSR细胞、Med 341细胞
293-EBNA Cells;背景说明:详见相关文献介绍;传代方法:1:4-1:10传代;每周2次。;生长特性:贴壁生长;形态特性:上皮细胞样;相关产品有:Calf Pulmonary Artery Endothelial细胞、NRK49F细胞、CBRH-7919细胞
MDAMB468 Cells;背景说明:该细胞是1977年由CailleauR等从一位患有转移性乳腺癌的51岁黑人女性的胸腔积液中分离得到的。虽然供体组织的G6PD等位基因杂合,但此细胞株始终表现为G6PDA表型。P53基因273位密码子存在G→A突变,从而导致Arg→His替代。每个细胞上存在1×106个EGF受体。;传代方法:1:2-1:4传代;2-3天换液1次;生长特性:贴壁生长;形态特性:上皮样;相关产品有:HT1080细胞、BC-023细胞、IM9细胞
Panc08.13 Cells;背景说明:详见相关文献介绍;传代方法:1:2传代;生长特性:贴壁生长;形态特性:上皮样;相关产品有:PC-3M-1E8细胞、MEL-526细胞、NIH3T3-L1细胞
U266 Cells;背景说明:详见相关文献介绍;传代方法:1:3传代,2-3天传一代;生长特性:悬浮生长 ;形态特性:淋巴母细胞样;相关产品有:MV-4-11细胞、H1993细胞、AZ-521细胞
NK92-MI Cells;背景说明:NK细胞;淋巴瘤;男性;传代方法:1:2-1:3传代;每周换液2-3次。;生长特性:悬浮;形态特性:详见产品说明书;相关产品有:MPP 89细胞、CHP 126细胞、BRL3A细胞
P3 NS1 Ag4 Cells;背景说明:这是P3X63Ag8(ATCCTIB-9)的一个不分泌克隆。Kappa链合成了但不分泌。能抗0.1mM8-氮杂鸟嘌呤但不能在HAT培养基中生长。据报道它是由于缺失了3-酮类固醇还原酶活性的胆固醇营养缺陷型。检测表明肢骨发育畸形病毒(鼠痘)阴性。;传代方法:1:2传代,3天内可长满。;生长特性:悬浮生长;形态特性:淋巴母细胞;相关产品有:Hs 706.T细胞、Hs 27细胞、RIN m5F细胞
┈订┈购(技术服务)┈热┈线:1┈3┈6┈4┈1┈9┈3┈0┈7┈9┈1【微信同号】┈Q┈Q:3┈1┈8┈0┈8┈0┈7┈3┈2┈4;
CHP126 Cells;背景说明:详见相关文献介绍;传代方法:1:2-1:3传代;每周换液2-3次。;生长特性:贴壁或悬浮,详见产品说明书部分;形态特性:详见产品说明书;相关产品有:HC-11细胞、TW 01细胞、NOZ细胞
MCF-7B Cells;背景说明:浸润性导管癌;胸腔积液转移;女性;传代方法:1:2-1:3传代;每周换液2-3次。;生长特性:贴壁;形态特性:详见产品说明书;相关产品有:Jurkat E6.1细胞、NCI522细胞、HEB细胞
Rat Chondrosarcoma Swarm Cells;背景说明:软骨肉瘤;SD;传代方法:1:2-1:3传代;每周换液2-3次。;生长特性:贴壁;形态特性:详见产品说明书;相关产品有:QGY 7701细胞、H-35 Reuber细胞、KE39细胞
HPF Cells;背景说明:肺;成纤维 Cells;传代方法:1:2-1:3传代;每周换液2-3次。;生长特性:贴壁;形态特性:详见产品说明书;相关产品有:HS-294-T细胞、NCI-H69C细胞、FHCRC-11细胞
IPEC-J2 Cells猪小肠上皮细胞批次新|送STR图谱
BayGenomics ES cell line GST159 Cells(提供STR鉴定图谱)
BayGenomics ES cell line XB269 Cells(提供STR鉴定图谱)
CGR8 Cells(提供STR鉴定图谱)
MANDOP21-3B9 Cells(提供STR鉴定图谱)
Royan N50 Cells(提供STR鉴定图谱)
TROMA-1 Cells(提供STR鉴定图谱)
"